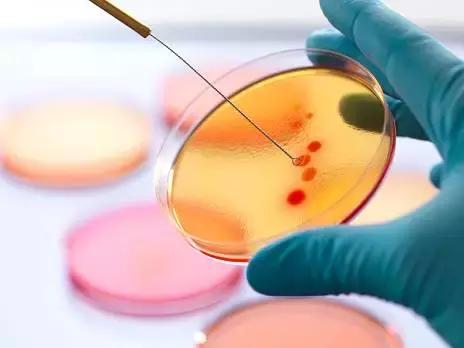
*霜砒**毒药还是药品，它治疗白血病，到底靠谱不靠谱？

白血病俗称“血癌”,其中急性早幼粒细胞白血病最凶险、病程发展最迅速,致死率很高,其特点是骨髓及其他造血组织中有大量白血病细胞无限制地增生并进入外周血液,家住无锡的王女士连续好几天牙龈出血不止,到医院检查血液之后发现血小板数量还不到正常人的五分之一。
而骨穿的结果证实,王女士得的是急性早幼粒细胞白血病,马上被安排住院。然而,开出的药方中,“三氧化二砷”这一药物吓到了本来就忧心忡忡的王女士。要知道,三氧化二砷就是我们常说的*霜砒**,*霜砒**可是毒药,为什么医生不用化疗而用毒药?
接诊的主任医师对给王女士开出的“三氧化二砷联合全反式维甲酸”这个治疗方案给出了解释:如果用化疗药,王女士估计很快就会出现脑出血,那可是致命的。

急性早幼粒细胞白血病和其他的白血病不同,最明显的特点是很容易出血,是最凶险的一种白血病,死亡率很高。化疗药是加速出血的催化剂,会加速病情恶化,在“*霜砒**”用于治疗这种白血病之前,有过太多教训。

什么是急性早幼粒细胞白血病
白血病俗称“血癌”,其中急性早幼粒细胞白血病最凶险、病程发展最迅速,致死率很高,其特点是骨髓及其他造血组织中有大量白血病细胞无限制地增生并进入外周血液,而正常血细胞的制造被明显抑制。
该病居年轻人恶性疾病中的首位,病因至今仍不完全清楚,病毒可能是主要的致病因子,但还有许多因素如放射、化学毒物(苯等)或药物、遗传素质等。我国关于白血病的治疗,基本是通过化疗来杀死病人体内的癌细胞。

针对急性早幼粒细胞白血病,在上世纪80年代之前,临床也尝试用化疗药物来杀死白血病细胞,结果发现,被杀死的白血病细胞会释放出一种物质,从而引起并加重患者的出血。
早幼粒细胞白血病的治疗历史
从前,国际上关于急性早幼粒细胞白血病(acute promyelocytic leukemia,简称APL)的主流方法是化疗,但死亡率较高,效果不够理想。上世纪80年代,由中国学者在国际上首次提出使用全反式维生A酸诱导分化治疗APL,并获得了成功。

目前维A酸(ATRA)诱导分化疗法主要用于APL,并已开始尝试于其他类型的AML及一些实体瘤维A酸对肿瘤细胞的作用机制与化疗药物不同,它通过促进APL细胞的分化纠正出凝血机制的异常,避免化疗所致的骨髓抑制和诱发DIC的可能,使白血病的治疗出现了重大的突破,使APL的预后大为改观。但只用全反式维甲酸治疗,绝大多数患者几个月后就会复发,所以研究者们依然在继续寻找其他可能有效的药。
中西医结合——新的突破
1993年,有学者提出了在维A酸(ATRA)诱导分化疗法的基础上使用砷剂As2O3——即中医中的剧毒药物*霜砒**,作为诱导成分的联合治疗方法。而在体外细胞培养的实验中发现,三氧化二砷对早幼粒细胞白血病有选择性作用,能诱导细胞一定程度的分化,这种分化程度跟维甲酸诱导的分化不太一样,三氧化二砷剂量比较大或作用时间比较长的时候,能引起细胞凋亡。

随着研究的深入,最终方案出炉,使急性早幼粒细胞白血病患者的 “五年无病生存率”从约25%跃升至约95%。这是一个非常大的进步。由于维甲酸和*霜砒**都有毒性,这项研究的进展伴随着争议和怀疑,但最终治疗成果说明了一切。
研究者认为,中医几千年临床实践中积累了很多朴素的辩证思想,积累了很多有用的药物和治疗技术,砷剂在中医中就有两千多年的历史,中医中的精华很多,正在不断发掘出来,青蒿素和人参皂苷就是很好的例子。

人参皂苷Rh2是从人参中提取的活性抗癌物质,能够增强患者的抵抗力,辅助各类白血病的治疗,除行骨髓移植手术患者皆可服用,其中又以含量为16%以上的人参皂苷Rh2最合人体吸收。
而作为我国研究中西医结合治疗白血病较早的单位,北京中科血康血液病医学研究院的首席专家史淑荣主任指出:中医药的清热解毒,软坚散结,补气养血的治疗原则对白血病有很好的作用,临床上研究的运用雄黄、青黛、白花蛇舌草、七叶一枝花、黄芪、灵芝、绞股蓝、大黄、山豆根等独特配方,临床上运用取得较好的疗效。